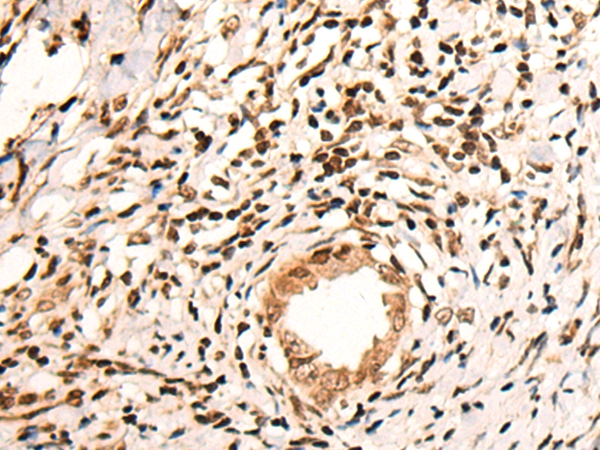
产品细节图片1

相关产品推荐更多 >
万千商家帮你免费找货
0 人在求购买到急需产品
- 详细信息
- 文献和实验
- 技术资料
- 免疫原:
Synthetic peptide corresponding to internal residues of human KMT2C
- 形态:
liquid
- 保存条件:
Store at -20˚C
- 克隆性:
Polyclonal
- 适应物种:
Human
- 保质期:
12 months
- 抗原来源:
Rabbit
- 供应商:
南京赛戈巍生物科技有限公司
- 宿主:
Rabbit
- 应用范围:
IHC
- 靶点:
Uniprot:Q8NEZ4
- 抗体英文名:
KMT2C Antibody
- 规格:
50ul/100ul
配方:Rabbit IgG in pH7.4 PBS, 0.05% NaN3, 40% Glycerol.
应用详情:
Immunohistochemistry: 1: 20-100
图片:
The image on the left is immunohistochemistry of paraffin-embedded Human cervical cancer tissue using 46594(KMT2C Antibody) at dilution 1/30, on the right is treated with synthetic peptide. (Original magnification: x200)
,

The image on the left is immunohistochemistry of paraffin-embedded Human tonsil tissue using 46594(KMT2C Antibody) at dilution 1/30, on the right is treated with synthetic peptide. (Original magnification: x200)
风险提示:丁香通仅作为第三方平台,为商家信息发布提供平台空间。用户咨询产品时请注意保护个人信息及财产安全,合理判断,谨慎选购商品,商家和用户对交易行为负责。对于医疗器械类产品,请先查证核实企业经营资质和医疗器械产品注册证情况。
文献和实验1、接好电源线并确定与有接地保护的电源插座相连。 2、按颜色接好电源槽和电泳仪的连接导线,并上好电泳样品。 3、开启电源开关。 4、此时数字显示屏交替显示“dyy”和“2c”字样,然后显示上次工作的设定值,可直接启动输出。 5、若要改变其数值可按上下键调节,若需持续改变,可按住按键不放松,当达到所需数字时松开即可。 6、希望查看并设定电流和定时时间,可按【选择】键,相应显示“mA”和“min”,其数值同样由调节键控制。 7、按【启动/停止】键后,仪器鸣响4声,输出启动,“输出指示
Mutation Detection in - and -Sarcoglycan (LGMD2E and LGMD2C)
Direct mutation analysis in the genes for β- and γ- sarcoglycan (SG) is performed in a patient in whom a type of autosomal recessive limb-girdle muscular dystrophy (LGMD) affecting the SG complex is suspected. Ideally, this suspicion
Distribution of 2A- and 2C-Adrenergic Receptor Immunoreactivity in the Central Nervous System
in the regulation of analgesia, memory, and central cardiovascular control (1 ). Three subtypes of the receptor have been identified (α2A -, α2B -, and α2C -ARs; for review, see ref. 2 ). Comparisons of the three subtypes show a high degree of sequence similarity
技术资料暂无技术资料 索取技术资料





![NOTCH3 Conjugated Antibody[C38587]](https://img1.dxycdn.com/p/s14/2025/0923/278/4431488150116040791.jpg!wh200)
![PTPN4 Antibody[37851]](https://img1.dxycdn.com/p/s14/2025/0922/359/6146153295428599691.jpg!wh200)
![TRAP220 Polyclonal Antibody[41513]](https://img1.dxycdn.com/p/s14/2025/0922/568/0046652811090600791.jpg!wh200)
![SEC23A Polyclonal Antibody[27613]](https://img1.dxycdn.com/p/s14/2025/0923/305/2150219664296040791.jpg!wh200)
![SLC37A4 Rabbit Polyclonal Antibody[53881]](https://img1.dxycdn.com/p/s14/2025/0922/498/0460884283108299691.jpg!wh200)

